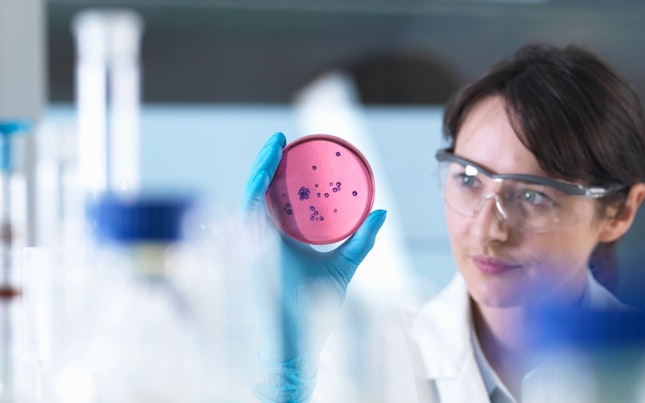
Scientist Examining Petri Dish

When moving forward into late phase clinical trials, you need access to highly specialized expertise and resources. Our comprehensive clinical trial management offers you tailor-made solutions and global coverage with local knowledge.
Our expertise in clinical trial management will ensure the success of your trial – helping you bring new products to market safely and quickly and prevent hurdles, such as inexperienced resources, inefficient feasibility and under-estimated start up.
We offer you:
- Project management, medical, feasibility, regulatory affairs and monitoring expertise
- An extensive network of clinical trial project management specialists, based in offices across Europe and North America
- An international reach and the expertise to respond to local regulations and partner with regional key opinion leaders
- Consistent, quality results and the help you need to reach your critical milestones on-time and within budget
- International and local clinical trial monitoring and management
- Subject matter experts across a range of therapeutic areas
- Consulting for full clinical development programs
- Study design and protocol writing
- Country specific feasibility studies
- Clinical site evaluation and selection
Our integrated clinical trial management services will ensure you have the right countries and sites identified and selected to get your study off to a flying start.
Contact us to discuss your clinical trial management requirements.
Looking for something specific?
Search within Clinical Trial Management